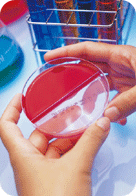
Experiment pictures

Oral Microbiology
Jeonbuk National University School of Dentistry's Major and Department
The Department of Oral Microbiology was established in 1992 with Dr. Yo-Han Song as the first chairman. Most dental diseases are caused by microbes such as bacteria and viruses. The main goal of the department research is to investigate the roles of microbes and their virulence factors in dental diseases and related systemic diseases. Development of vaccines against dental diseases is also included in our interesting research fields.
PROFESSOR
- Professor : Kyung-Yeol Lee, PhD.
RESEARCH AREAS
- Identification and characterization of virulence factors of periodontogenic and cariogenic bacteria
- Development of vaccines against oral diseases
- Study on the mechanism of systemic inflammatory diseases by oral pathogens
